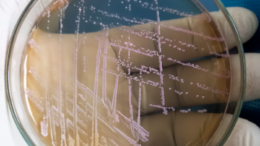

Fecal Transplantation Shown to be an Effective Remedy for Life-Threatening Intestinal Infections
Fecal transplantation in the intestine is an effective cure – and far superior to today’s standard treatment – for a life-threatening infection that affects between 2,500 and 3,000 people in…